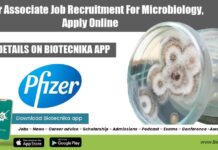
Pfizer Associate Job Recruitment For Microbiology, Apply Online Pfizer Associate Job Recruitment

Free Download: 6 Month Master Study Planner for CSIR NET Life Sciences Dec 2025...
Free Download: 6-Month Study Planner for CSIR NET Life Sciences Exam (Old + New Syllabus)
Are you preparing for the CSIR NET Life Sciences Dec...
Life Sciences Apply For Consultant Post at Medifirm Intelledge Global Private Limited, Apply on...
PhD Life Sciences Vacancies Latest at Medifirm Intelledge Global Private Limited
Job Title: Consultant – Life Sciences
Location: Gurugram Hybrid (Flexible)
Company: Medifirm Intelledge Global Private Limited
Experience:...
C-CAMP Hiring Life Sciences & Biotech Candidates For Production Operator Role, Apply on Biotecnika
Life Sciences BSc Jobs
Job Title: Cleanroom Production Operator (Senior Level)
Company Name: C-CAMP Bangalore (Research Foundation)
Experience: 2 – 3 years
CTC: Above 30K OR (Hike on...
URGENT HIRING: C-CAMP Biotech & Life Sciences Job Openings – Apply Exclusively on Biotecnika
MSc Biotechnology Job Vacancies at C-CAMP
Job Title: Cleanroom Production Operator (Senior Level)
Company Name: C-CAMP Bangalore (Research Foundation)
Experience: 1 year
CTC: (Hike on their current CTC)...
Enzyme Development Intern at Technoculture Research – Apply Only on Biotecnika
BSc Biochemistry Internships at Technoculture Research
Role: Enzyme Development Intern
Company: Technoculture Research
Location: Bodhgaya, Bihar
Type: Internship (Full-Time)
Duration: 6 Months
Internship Description
Technoculture Research is looking for a motivated...
ProPharma Hiring for Pharmacovigilance Specialist – Case Processing Role – Life Sciences Apply Exclusively...
BSc Life Sciences Jobs in Pharmacovigilance
Pharmacovigilance Specialist – Case Processing
Location: Hebbal, Bangalore, India
Company: ProPharma
Experience Required: 2 Years
Salary Range: ₹5 – ₹6 LPA
Employment Type: Full-Time
Interview...
Freshers Life Sciences Clinical Research Associate Job at NIRAMAI Health Analytix Pvt. Ltd., Apply...
Freshers CRA Jobs For Life Sciences at NIRAMAI Health Analytix Pvt. Ltd.
Job Title: Clinical Research Associate
Location: Mumbai
Experience: 0–1 Year
Salary: ₹2.4 LPA
Interview Mode: Online
Company: NIRAMAI...
Register FREE For GATE 2026 Kickstarter Webinar – Master Its Syllabus, Learn Pro Tips...
GATE 2026 Kickstarter Webinar – Master Its Syllabus with Pro Tips
DOWNLOAD GATE 2026 STUDY PLANNER
Join the exclusive FREE GATE 2026 Kickstart Webinar on 11th...
MSc Biotech Jobs at Merck – Apply Now for the Assistant Quality Control Role
MSc Biotech Jobs at Merck - Apply Now for the Assistant Quality Control Role
Join a global leader in science and technology that is transforming...
Research Associate Position at IISER Mohali – MSc Life Science Graduates Attend the Walk-In...
Research Associate Position at IISER Mohali - MSc Life Science Graduates Attend the Walk-In Interview
IISER Mohali’s Department of Biological Sciences invites eligible candidates to...
Microbiologist Job at Apollo Hospitals | Bachelors Candidates Apply Now For The Role
Microbiologist Job at Apollo Hospitals | Bachelor's Candidates Apply Now For The Role
Join Apollo Hospitals, Chennai, as a Microbiologist and contribute to world-class healthcare...
Associate Editor Jobs at Springer Nature | PhD Life Science Candidates Apply Online
Associate Editor Jobs at Springer Nature l PhD Life Science Candidates Apply Online
Springer Nature, a global leader in academic publishing, is seeking talented professionals...
Project Associate Position at IISER Mohali – MSc Life Science Graduates Attend the Walk-In...
Project Associate Position at IISER Mohali - MSc Life Science Graduates Attend the Walk-In Interview
IISER Mohali’s Department of Biological Sciences invites eligible candidates to...
Project Associate Position at NIBMG – MSc Life Science Graduates Apply Online
Project Associate Position at NIBMG - MSc Life Science Graduates Apply Online
The National Institute of Biomedical Genomics (NIBMG) invites applications for the position of...
Research Fellow Positions at CCRH | Walk-In Interview For MSc Life Science Candidates |...
Research Fellow Positions at CCRH | MSc Life Science Candidates Attend the Walk-In Interview
Are you a qualified post-graduate in Life Sciences or Homoeopathy looking...